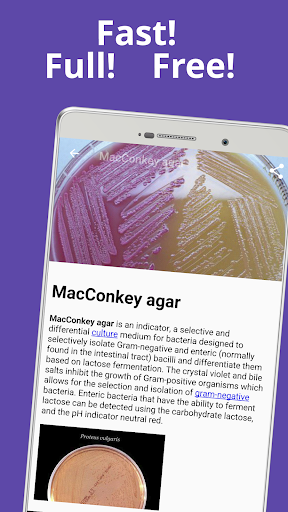

- Applications
- Education
Cell biology

| Install | +50 |
| From 0 Rates | 0 |
| Category | Education |
| Size | 41 MB |
| Last Update | 2025 February 8 |

| Install | +50 |
| From 0 Rates | 0 |
| Category | Education |
| Size | 41 MB |
| Last Update | 2025 February 8 |
Images

Introduction
Big scientific encyclopedia "Cell biology" - meiosis and mitosis, cytokines, cellular processes, signaling, movement, growth factors, etc.
Cell biology (also cellular biology or cytology) - the science of cells. The subject of cytology is the cell as a structural and functional unit of life. The tasks of cytology include the study of the structure and functioning of cells, their chemical composition, functions of individual cellular components, processes of cell reproduction, adaptation to environmental conditions, study of the structural features of specialized cells, etc. Research in cellular biology is interconnected to other fields such as genetics, molecular genetics, biochemistry, molecular biology, medical microbiology, immunology, and cytochemistry.
Organelles are permanent intracellular structures that differ in structure and perform various functions. Organelles are subdivided into membrane (two-membrane and one-membrane) and non-membrane. The two-membrane components are plastids, mitochondria and the cell nucleus. The organelles of the vacuolar system are one-membrane organelles - the endoplasmic reticulum, the Golgi complex, lysosomes, vacuoles of plant and fungal cells, pulsating vacuoles, etc. Nonmembrane organelles include the ribosomes and the cell center, which are constantly present in the cell.
Mitochondria are integral components of all eukaryotic cells. They are granular or threadlike structures. Mitochondria are bounded by two membranes - the outer and the inner. The outer mitochondrial membrane separates it from the hyaloplasm. The inner membrane forms many invaginations inside the mitochondria - the so-called cristae.
Mitosis is a method of cell division in which genetic material (chromosomes) is distributed equally between new (daughter) cells. It starts by dividing the core into two children. The cytoplasm is similarly divided. The processes that take place from one division to another are called the mitotic cycle.
Meiosis is a stage in the formation of germ cells; consists of two successive divisions of the original diploid cell (containing two sets of chromosomes) and the formation of four haploid germ cells, or gametes (containing one set of chromosomes).
The cytoskeleton, a set of filamentous protein structures - microtubules and microfilaments that make up the musculoskeletal system of the cell. The cytoskeleton is possessed only by eukaryotic cells; it is absent in the cells of prokaryotes (bacteria). The cytoskeleton gives the cell a certain shape even in the absence of a rigid cell wall. It organizes the movement of organelles in the cytoplasm. The cytoskeleton is easily rearranged, providing, if necessary, a change in the shape of the cells.
Amino acids are the structural components of proteins. Proteins are biological heteropolymers, the monomers of which are amino acids. About 200 amino acids are known to be found in living organisms, but only 20 of them are part of proteins. These are basic, or protein-forming (proteinogenic), amino acids.
By their chemical nature, enzymes are simple or complex proteins; their molecules may include a non-protein part - a coenzyme. The mechanism of action of enzymes is to reduce the activation energy of the catalyzed reaction. This is achieved by attaching the enzyme to the reacting substances and forming an intermediate complex with them, as a result of which the energy threshold of the reaction decreases and the probability of its proceeding in the desired direction sharply increases.
This science dictionary cellular biology book free offline:
• contains over 7500 definitions of characteristics and terms;
• ideal for professionals, students and hobbyists alike;
• advanced search function with autocomplete - search will start and predict word as you type;
• voice search;
• work offline - database packaged with the app, no data costs incurred when searching;
• is an ideal app for quick reference or book to learn biology.
Related Applications










Users Also Installed










Similar Applications










